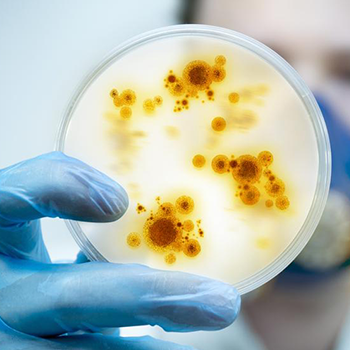

Por primera vez en el mundo una infección mortal es tratada con virus transgénicos que cazan bacterias.
Una adolescente británica, Isabelle Carnell-Holdaway, ha conseguido salvar su vida gracias a un nuevo tratamiento que utiliza un virus modificado. La joven estaba diagnosticada de fibrosis quística, una enfermedad genética que le provocaba infecciones frecuentes que obstruían sus pulmones.
La nueva técnica empleada ha consistido en tratar a la paciente con un virus genéticamente diseñado para ‘cazar’ bacterias, y su logro ha sido reseñado en la revista científica Nature, que califica de «emocionante artículo» el texto que describe el «primer uso clínico de los fagos diseñados para tratar una infección resistente a los antibióticos».
A los 15 años la joven fue sometida a un doble trasplante de pulmón, y la bacteria Mycobacterium abscessus, que ya la había infectado antes, regresó. Cuando eso sucede, en la mayoría de los casos el paciente muere. Y lo cierto es que la infección de la herida quirúrgica de Isabelle ya se había extendido a su hígado y pulmones.
De hecho, mientras luchaba por su vida en el hospital londinense Great Ormond Street (GOSH), cuando los antibióticos ya no hacían ningún efecto, los médicos dijeron que «no iba a salir del hospital y que tenía menos del 1 % de posibilidades de supervivencia», cuenta la madre de Isabelle, Jo Holdaway, a The Independent.
Ahora, a los 17 años, Isabelle está aprendiendo a conducir y comienza a llevar la vida normal de una adolescente de su edad.
Terapia con bacteriofagos.
Los fagos, también conocidos como bacteriófagos, son una clase de virus que infecta las células de las bacterias en lugar de las del cuerpo. Los fagos se instalan en la superficie de la bacteria, le introduce su propio código genético, se reproduce dentro de ella y acaban destruyéndola.
La terapia con fagos se ha conocido durante casi un siglo, pero tenía un uso muy limitado. El caso de esta adolescente británica ha sido el primero en utilizar esta técnica la ingeniería genética, además de ser la primera persona tratada por una infección de microbacterias con terapia de fagos.
Los padres de Isabelle habían leído sobre esta terapia en una infección diferente y propusieron la opción al equipo médico que trataba a su hija. Aceptando la propuesta, el GOSH tomó la decisión de enviar muestras de la infección de la adolescente a la Universidad de Pittsburgh.
Esta universidad norteamericana tiene una colección de más de 15.000 cepas identificadas de bacteriófagos, pero ninguna era la candidata perfecta para Isabelle. Así que apostaron por un ‘cóctel’ de tres virus, dos de los cuales tuvieron que modificar genéticamente, para aumentar su efectividad.

En la Imagen: Un virus bacteriófago observado por micrografía electrónica, La estructura hexagonal de la parte superior de la imagen contiene el ADN del virus, Las fibras de la parte inferior permiten al virus fijarse a las bacterias que infecta (DEPT. OF MICROBIOLOGY, BIOZENTRU / Getty)
En junio de 2018, los médicos administraron el cóctel al paciente por vía intravenosa dos veces al día con mil millones de partículas de fago en cada dosis. Después de seis semanas, una exploración del hígado reveló que la infección había desaparecido esencialmente. Hoy solo quedan uno o dos nódulos cutáneos de la niña. Hatfull tiene grandes esperanzas: las bacterias no han mostrado ningún signo de desarrollo de resistencia a los fagos, y su equipo ha preparado un cuarto fago para agregar a la mezcla.
Encontrar los fagos adecuados para cada paciente es un gran desafío, dice Hatfull. Un día, los científicos podrán elaborar un cóctel de fagos que funciona más ampliamente para tratar enfermedades, como las infecciones por Pseudomonas que amenazan a los pacientes con quemaduras.
«Estamos en un territorio desconocido», dice. Pero los fundamentos del caso de la joven son bastante simples, agrega. «Purificamos los fagos, se los dimos al paciente y el paciente mejoró».
Fuente: Howard Hughes Medical Institute.
Referencia: Nature Medicine.
Fuente:
COMUNIDAD BIOLÓGICA